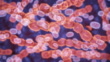

Bacteria Lactococcus - 4K stock video
Lactococcus bacteria,Good microorganisms concept

PURCHASE A LICENSE
All Royalty-Free licenses include global use rights, comprehensive protection, simple pricing with volume discounts available
€475.00
EUR
DETAILS
Credit:
51³Ô¹ÏÍø #:
1405455928
License type:
Collection:
Creatas Video
Max file size:
3840 x 2160 px - 1 GB
Clip length:
00:00:14:00
Upload date:
Location:
Thailand
Release info:
No release required
Mastered to:
QuickTime 10-bit ProRes 422 (HQ) 4K 3840x2160 30p
Categories:
- Microscope,
- Fermenting,
- Intestine,
- Laboratory,
- Bacterium,
- Biological Cell,
- Illness,
- Meningitis,
- 4K Resolution,
- Abdomen,
- Acid,
- Anaerobic,
- Antibiotic,
- Bacillus Subtilis,
- Binary Code,
- Biology,
- Biology Class,
- Biotechnology,
- Blood Clot,
- Bronchitis,
- Buttermilk,
- Cheese,
- Cold And Flu,
- Colon,
- Contamination,
- Dividing,
- Division,
- Endocarditis,
- Film - Moving Image,
- Food,
- Futuristic,
- Gram-positive Bacteria,
- HD Format,
- Healthcare And Medicine,
- Horizontal,
- Industry,
- Medical Research,
- Medicine,
- Micro Organism,
- Microbiology,
- Microbiome,
- Milk,
- Non US Film Location,
- Pathogen,
- Pneumonia,
- Positive Emotion,
- Probiotic,
- Prokaryote,
- Real Time Video,
- Science,
- Streptococcus,
- Thailand,
- Unhygienic,
- Virtual Reality,
- Yogurt,